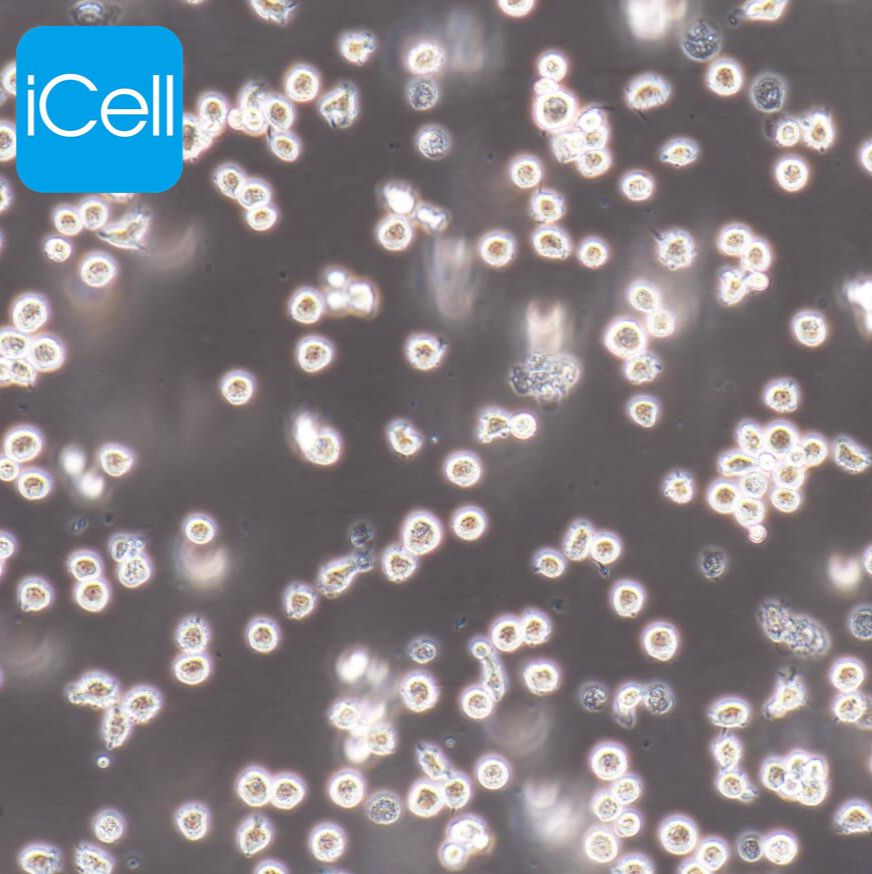
产品封面图

相关产品推荐更多 >
万千商家帮你免费找货
0 人在求购买到急需产品
- 详细信息
- 询价记录
- 文献和实验
- 技术资料
- 英文名:
HL-60
- 库存:
100
- 供应商:
镜像绮点
- 肿瘤类型:
单核细胞白血病
- 细胞类型:
细胞系
- ATCC Number:
-
- 品系:
细胞系
- 组织来源:
外周血
- 相关疾病:
单核细胞白血病
- 物种来源:
组织
- 免疫类型:
否
- 细胞形态:
原粒细胞
- 是否是肿瘤细胞:
是
- 器官来源:
外周血
- 运输方式:
冻存/复苏
- 年限:
长期
- 生长状态:
悬浮生长
- 规格:
T25
HL60 人早幼粒白血病细胞/STR鉴定
细胞介绍
HL-60是一株早幼粒细胞。外周血白细胞来自一位患有急性粒-单核细胞白血病的36岁白人女性。 HL-60 自发分化,丁酸盐、次黄嘌呤、佛波醇肉豆蔻酸、DMSO(1% to 1.5%)、放线jun素D和视黄酸可以促进分化。细胞表现出吞噬活性,并对趋化刺激有响应。致癌基因myc表达阳性。
细胞特性
1) 来源:外周血;早幼粒细胞;急性粒-单核细胞白血病
2) 形态:原粒细胞,悬浮生长
3) 含量:>1x10^6 个/mL
4) 污染:支原体、细菌、酵母和真菌检测为阴性
5) 规格:T25瓶或者1mL冻存管包装
细胞培养步骤
一.培养基及培养冻存条件准备:
1) 准备IMDM(推荐iCell-0008)培养基;优质胎牛血清,20%;双抗1%。
2) 培养条件: 气相:空气,95%;二氧化碳,5%。 温度:37摄氏度,培养箱湿度为70%-80%。
3) 冻存液:90%血清,10%DMSO,现用现配。
业务范围



风险提示:丁香通仅作为第三方平台,为商家信息发布提供平台空间。用户咨询产品时请注意保护个人信息及财产安全,合理判断,谨慎选购商品,商家和用户对交易行为负责。对于医疗器械类产品,请先查证核实企业经营资质和医疗器械产品注册证情况。
- 作者
- 内容
- 询问日期
文献和实验查看细胞文献:www.icellbioscience.com
Sphingomyelin Quantitation Post-choline Labeling of HL60 Cells
Lipid Extraction 1) Following the appropriate time of treatment, transfer 4.5 ml into each of two duplicate glass pyrex tubes and maintain on ice. 2) Spin down cells in the table top centrifuge at 1,200 rpm, 40C, for 5 minutes.
Sphingomyelin Quantitation Post-choline Labeling of HL60 Cells
Sphingomyelin Quantitation Post-choline Labeling of HL60 Cells Contributor: Suprya Jayadev Date: Jun. 16, 1992 Reagents TMT buffer: 0.19 M Tris-HCl (pH 7.4-7.6) 12 mM MgCl2 0.2 % Triton X-100 SMase solution
在基因诊断方面具有很大的应用潜力。Cloud等人利用激光捕捉显微切割技术,联合蛋白质芯片研究了正常人、结肠癌病人、癌转移病人结肠组织蛋白 的表达情况,发现了不同的表达图谱。Tarui等人用DNA芯片分析了烧伤病人淋巴细胞中细胞因子基因的表达情况,发现IFNrR1,IL1R1,-2Rh,-2Ra,-2Rr,-6Ra和-7R降低,IFN-r,IL-1a,-13和-15表达升高,从而为烧伤病人的治疗提供依据。Song等人绘制了早幼粒细胞性白血病HL-60细胞向单核细胞或者粒细胞分化过程中的一些肿瘤
技术资料